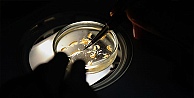
133 yeni canlı türü!

Öne Çıkan Haberler

Kaybolan 70 yaşındaki adam 20 saatlik arama sonucunda sağ bulundu

UCLG-MEWA CSCUM Çevrimiçi Başkanlık Toplantısı Gebze Ev Sahipliğinde Gerçekleştirildi

Başkan Büyükgöz, Muhtar Ziyaretlerine Devam Ediyor

Seyir halindeki yolcu otobüsünde yangın: Facia son anda önlendi

Yapay zekayla kadın olup vurgun yapmışlar
- Kocaeli Büyükşehir Belediye Başkanı Tahir Büyükakın, Aile Yılı Çalışmalarını Devr-i Alem Programına Anlattı
- Kocaeli'de yolcu otobüsü şarampole yuvarlandı
- Şehir Tiyatroları’na İnegöl’de alkış yağmuru
- Bahçem Çayırova’da teraryum atölyesi gerçekleştirildi
- KOCAELİ MİLLETVEKİLİ SAMİ ÇAKIR VE İLÇE BAŞKANI RECEP KAYA’DAN İKTAV’A ZİYARET
Son Yorumlar




 Gönderi: 1980’den Beri Süzülen Bir Kalite ve Stil Mirası
Gönderi: 1980’den Beri Süzülen Bir Kalite ve Stil Mirası Saadet Partisi Kocaeli İl Başkanı Recep Sarıdoğan İKTAV Kütüphanesi’ni Ziyaret Etti
Saadet Partisi Kocaeli İl Başkanı Recep Sarıdoğan İKTAV Kütüphanesi’ni Ziyaret Etti Başkan Büyükgöz, Muhtar Ziyaretlerine Devam Ediyor
Başkan Büyükgöz, Muhtar Ziyaretlerine Devam Ediyor Kocaeli’de Atlas Çağlayan İçin Adalet Yürüyüşü Düzenlenecek
Kocaeli’de Atlas Çağlayan İçin Adalet Yürüyüşü Düzenlenecek Gebze Belediyesi ev sahipliğinde UCLG-MEWA CSCUM Başkanlık Toplantısı Yapıldı
Gebze Belediyesi ev sahipliğinde UCLG-MEWA CSCUM Başkanlık Toplantısı Yapıldı Kocaeli Büyükşehir Belediye Başkanı Tahir Büyükakın, Aile Yılı Çalışmalarını Devr-i Alem Programına Anlattı
Kocaeli Büyükşehir Belediye Başkanı Tahir Büyükakın, Aile Yılı Çalışmalarını Devr-i Alem Programına Anlattı Çayırova Zabıtası Halk Sağlığını Tehdit Eden İşletmeyi Mühürledi
Çayırova Zabıtası Halk Sağlığını Tehdit Eden İşletmeyi Mühürledi Türk Tiyatrosunun Usta İsmi Haldun Dormen Hayatını Kaybetti
Türk Tiyatrosunun Usta İsmi Haldun Dormen Hayatını Kaybetti İzmit Akçakoca’daki Metruk Tarihi Evler İçin Restorasyon Çağrısı
İzmit Akçakoca’daki Metruk Tarihi Evler İçin Restorasyon Çağrısı CHP Kocaeli Milletvekili Harun Özgür Yıldızlı, Vali İlhami Aktaş’ı Ziyaret Etti
CHP Kocaeli Milletvekili Harun Özgür Yıldızlı, Vali İlhami Aktaş’ı Ziyaret Etti MHP, DEM Parti ile bayramlaştı
MHP, DEM Parti ile bayramlaştı Çayırova Kent Meydanı paylaşımına Baran Aydın’dan tepki
Çayırova Kent Meydanı paylaşımına Baran Aydın’dan tepki 'Milletimizin ekonomi ve huzur orucu Yeniden Refah ile açılacaktır'
'Milletimizin ekonomi ve huzur orucu Yeniden Refah ile açılacaktır' KAYA: "GENÇLERİ OKUMAYA VE ÖĞRENMEYE TEŞVİK ETMELİYİZ"
KAYA: "GENÇLERİ OKUMAYA VE ÖĞRENMEYE TEŞVİK ETMELİYİZ" CHP Kadın Kolları Başkanı Merve Tüysüz'den açıklama
CHP Kadın Kolları Başkanı Merve Tüysüz'den açıklama İYİ Parti Kocaeli Kadın Koları Başkanı Rüzgar'dan açıklama
İYİ Parti Kocaeli Kadın Koları Başkanı Rüzgar'dan açıklama Dilovası’nda Esnaf ve Vatandaşların Sorunları Dinlendi
Dilovası’nda Esnaf ve Vatandaşların Sorunları Dinlendi AK Kadın Darıca kongreye gidiyor
AK Kadın Darıca kongreye gidiyor Otomobil bariyere saplandı: Sürücü yara almadan kurtuldu
Otomobil bariyere saplandı: Sürücü yara almadan kurtuldu Kocaeli’de atık naylon deposunda yangın
Kocaeli’de atık naylon deposunda yangın Taciz iddiasıyla vurulan halterci: "Sporculuk hayatımı bitirdiler, 1 ay sonra milli takıma girecektim"
Taciz iddiasıyla vurulan halterci: "Sporculuk hayatımı bitirdiler, 1 ay sonra milli takıma girecektim" Kulübede balta ve kürekle öldürülen berberin vücudunda 24 yara tespit edildi
Kulübede balta ve kürekle öldürülen berberin vücudunda 24 yara tespit edildi Otoparktaki cinayetin şüphelisinin ifadesi ortaya çıktı: "Korkutmak istedim"
Otoparktaki cinayetin şüphelisinin ifadesi ortaya çıktı: "Korkutmak istedim" Kocaeli'de istinat duvarından düşen otomobildeki anne ve kızı yaralandı
Kocaeli'de istinat duvarından düşen otomobildeki anne ve kızı yaralandı Eğitim kurumlarının geleceğine Büyükşehir desteği
Eğitim kurumlarının geleceğine Büyükşehir desteği Akademi Liseler, öğrencileri yazılı sınavlara da hazırlıyor; Kocaeli Büyükşehir’le adım adım başarıya
Akademi Liseler, öğrencileri yazılı sınavlara da hazırlıyor; Kocaeli Büyükşehir’le adım adım başarıya Kocaeli’de Eğitime 1 Gün Kar Tatili
Kocaeli’de Eğitime 1 Gün Kar Tatili Büyükşehir, 2025’te insan kaynakları ve eğitimde büyük adımlar attı; 7 bin 931 personele 100’ü aşkın eğitim
Büyükşehir, 2025’te insan kaynakları ve eğitimde büyük adımlar attı; 7 bin 931 personele 100’ü aşkın eğitim Kocaeli Büyükşehir’le ilk yardım öğren, hayat kurtar; 2025’te 7 bin vatandaşa ilk yardım eğitimi
Kocaeli Büyükşehir’le ilk yardım öğren, hayat kurtar; 2025’te 7 bin vatandaşa ilk yardım eğitimi Çayırova’da afetlere hazırlık eğitimi verildi; Büyükşehir, Çayırova’yı olası afetlere hazırladı
Çayırova’da afetlere hazırlık eğitimi verildi; Büyükşehir, Çayırova’yı olası afetlere hazırladı TEKNOFEST öğrencileri güvenli çalışma ve ilk yardım eğitimi aldı; Güvenli çalışma kültürü Büyükşehir’le güçleniyor
TEKNOFEST öğrencileri güvenli çalışma ve ilk yardım eğitimi aldı; Güvenli çalışma kültürü Büyükşehir’le güçleniyor Sınıf Başkanının seçim vaadi Büyükakın’dı: Öğrenciler büyük sevinç yaşadı
Sınıf Başkanının seçim vaadi Büyükakın’dı: Öğrenciler büyük sevinç yaşadı Gebze Belediyesi’nden Yeni Eğitim Hamlesi: “Cevher Çocuk Projesi” Duyuruldu
Gebze Belediyesi’nden Yeni Eğitim Hamlesi: “Cevher Çocuk Projesi” Duyuruldu Küçük Duru, güçlü kulaçlarıyla suyun tadını çıkartıyor; Gonca’da hidroterapi tedavisi hayatları değiştiriyor
Küçük Duru, güçlü kulaçlarıyla suyun tadını çıkartıyor; Gonca’da hidroterapi tedavisi hayatları değiştiriyor Bebeğinizin İlk Lezzetleri için Doğal ve Güvenilir Bir Adres
Bebeğinizin İlk Lezzetleri için Doğal ve Güvenilir Bir Adres Çetin Günay: Gözlük Sektörüne Adanmış Bir Ömür ve Stilin Öncüsü
Çetin Günay: Gözlük Sektörüne Adanmış Bir Ömür ve Stilin Öncüsü Anne Şehir ile adım adım sağlığa
Anne Şehir ile adım adım sağlığa Hacamat Yaptırmadan Önce Bilinmesi Gerekenler
Hacamat Yaptırmadan Önce Bilinmesi Gerekenler Büyükakın: “Sağlıklı bir yaşam için hareketlilik şart”
Büyükakın: “Sağlıklı bir yaşam için hareketlilik şart” Anne Şehir’den bel sağlığı için öneriler
Anne Şehir’den bel sağlığı için öneriler Allurion Mide Balonu
Allurion Mide Balonu Uzmanından kadınlara uyarı: "Diz ağrısını hafife almayın"
Uzmanından kadınlara uyarı: "Diz ağrısını hafife almayın" Akaryakıt Ödeme Kolaylığı ile Zamanınız Sizin Olsun
Akaryakıt Ödeme Kolaylığı ile Zamanınız Sizin Olsun Çin Merkez Bankası Uyarısı Kripto Piyasasında Satışları Hızlandırdı
Çin Merkez Bankası Uyarısı Kripto Piyasasında Satışları Hızlandırdı Güvenilir Plywood Üreticisi Nasıl Seçilir?
Güvenilir Plywood Üreticisi Nasıl Seçilir? Kale Kilit, Avrasya Pencere, Kapı ve Cam Fuarı’nda Yeni Ürünleriyle Yoğun İlgi Gördü
Kale Kilit, Avrasya Pencere, Kapı ve Cam Fuarı’nda Yeni Ürünleriyle Yoğun İlgi Gördü Kocaeli’de 18 Kasım’da İki Önemli Etkinlik Düzenlenecek
Kocaeli’de 18 Kasım’da İki Önemli Etkinlik Düzenlenecek KOTO 22. Meslek Komitesi’nden ‘Sigortacılık Haftası’ kutlama mesajı
KOTO 22. Meslek Komitesi’nden ‘Sigortacılık Haftası’ kutlama mesajı Uzun Dönem Ticari Araç Kiralama ile İşletmenizi Güçlendirin
Uzun Dönem Ticari Araç Kiralama ile İşletmenizi Güçlendirin Hyundai Motor Türkiye’den üniversite öğrencileri için staj fırsatı
Hyundai Motor Türkiye’den üniversite öğrencileri için staj fırsatı Demir Çelik Sektörü, Yıldız Demir Çelik’in Platin Sponsorluğunda Steelorbis Etkinliğinde Buluştu
Demir Çelik Sektörü, Yıldız Demir Çelik’in Platin Sponsorluğunda Steelorbis Etkinliğinde Buluştu Büyükşehir, kültür ve sanat dolu bir geceye imza attı; Anadolu’nun ritmi Kocaeli’de yankılandı
Büyükşehir, kültür ve sanat dolu bir geceye imza attı; Anadolu’nun ritmi Kocaeli’de yankılandı GEBZE BELEDİYESİ’NDEN ARA TATİLE ÖZEL ÇOCUK ETKİNLİKLERİ
GEBZE BELEDİYESİ’NDEN ARA TATİLE ÖZEL ÇOCUK ETKİNLİKLERİ GKM’de Sanat Dolu Hafta Sonu
GKM’de Sanat Dolu Hafta Sonu Saygınlar, Mevlevi kültürüyle buluştu
Saygınlar, Mevlevi kültürüyle buluştu Şehir Tiyatroları’na İnegöl’de alkış yağmuru
Şehir Tiyatroları’na İnegöl’de alkış yağmuru Büyükşehir Anne Şehir Kadın Korosu’ndan muhteşem konser
Büyükşehir Anne Şehir Kadın Korosu’ndan muhteşem konser Büyükşehir, çocukların hayal dünyasını zenginleştiriyor; “Masalın Sesi” tiyatroyu farklı bir boyutla tanıtıyor
Büyükşehir, çocukların hayal dünyasını zenginleştiriyor; “Masalın Sesi” tiyatroyu farklı bir boyutla tanıtıyor Büyükşehir’den “Ortak Miras Tek Yürek” kültür etkinliği
Büyükşehir’den “Ortak Miras Tek Yürek” kültür etkinliği “Üç Jokerli Konken” Gebze’de seyirciyle buluştu
“Üç Jokerli Konken” Gebze’de seyirciyle buluştu Kandıra’da Spor Hamlesi: 5 Halı Saha Çalışması Başladı
Kandıra’da Spor Hamlesi: 5 Halı Saha Çalışması Başladı Türkiye Boks Şampiyonası Darıca’da yapılacak
Türkiye Boks Şampiyonası Darıca’da yapılacak Çayırova Belediyesi, Federasyon Kupası şampiyonu
Çayırova Belediyesi, Federasyon Kupası şampiyonu Trabzonspor ve Kocaelispor, stadyuma giriş yaptı
Trabzonspor ve Kocaelispor, stadyuma giriş yaptı Çayırova Belediyesi, Federasyon Kupası’nda finale yükseldi
Çayırova Belediyesi, Federasyon Kupası’nda finale yükseldi Çayırova Belediyesi, Federasyon Kupası’nda yarı finalde
Çayırova Belediyesi, Federasyon Kupası’nda yarı finalde Çayırova Belediyesi’nden kupa mesaisi
Çayırova Belediyesi’nden kupa mesaisi Kağıtspor, 2025’e 317 madalya sığdırdı
Kağıtspor, 2025’e 317 madalya sığdırdı Çayırova Belediyesi, 2026’ya galibiyetle başladı
Çayırova Belediyesi, 2026’ya galibiyetle başladı Sadakatin Gücünü Keşfedin: GFC Loyalty ile İlişkilerinizi Taçlandırın
Sadakatin Gücünü Keşfedin: GFC Loyalty ile İlişkilerinizi Taçlandırın Çiçek Buketi Siparişi Verirken En Çok Yapılan Hatalar
Çiçek Buketi Siparişi Verirken En Çok Yapılan Hatalar Nikah Elbisesi
Nikah Elbisesi Türk Kahvesi: Bir Fincana Sığan Kültür, Tat ve Deneyim Rehberi
Türk Kahvesi: Bir Fincana Sığan Kültür, Tat ve Deneyim Rehberi Aydınç Kozmetik ile Güvenli ve Kazançlı Toptan Kozmetik Alımı
Aydınç Kozmetik ile Güvenli ve Kazançlı Toptan Kozmetik Alımı Evinizin Konforu İçin Güvenilir Bir Adres: Online Kombi
Evinizin Konforu İçin Güvenilir Bir Adres: Online Kombi Filo Yönetiminde Güvenilir Çözüm Ortağınız
Filo Yönetiminde Güvenilir Çözüm Ortağınız Kozmela ile Güzelliğin ve Sağlığın Yeni Adresine Hoş Geldiniz
Kozmela ile Güzelliğin ve Sağlığın Yeni Adresine Hoş Geldiniz Kandıra’nın Katçalı Köyü Geleneklerini Yaşatarak Örnek Oluyor
Kandıra’nın Katçalı Köyü Geleneklerini Yaşatarak Örnek Oluyor TÜRKİYE DEPREM VAKFI KÜTÜPHANESİNİN BULUNDUĞU GTÜ DEN CANLI YAYINDA
TÜRKİYE DEPREM VAKFI KÜTÜPHANESİNİN BULUNDUĞU GTÜ DEN CANLI YAYINDA TGRT DE YAYINLANAN YAYINLANAN VAKIF MEDENİYETİ BELGESELİ BÜYÜK İLGİ GÖRÜYOR
TGRT DE YAYINLANAN YAYINLANAN VAKIF MEDENİYETİ BELGESELİ BÜYÜK İLGİ GÖRÜYOR GTO DAN DEPREM ETKİNLİĞİ
GTO DAN DEPREM ETKİNLİĞİ TGRT DE SIRBİSTANDA OSMANLI VAKIF MEDENİYETİ TARİHİ BELGESELİ YAYINLANIYOR
TGRT DE SIRBİSTANDA OSMANLI VAKIF MEDENİYETİ TARİHİ BELGESELİ YAYINLANIYOR KANDIRANIN KAZA MERKEZİ OLUŞUNUN 500. YILI KUTLANMALI
KANDIRANIN KAZA MERKEZİ OLUŞUNUN 500. YILI KUTLANMALI KANDIRA KEFKEN ADASINDAN CANLI MAKALE VE HABER
KANDIRA KEFKEN ADASINDAN CANLI MAKALE VE HABER Karamürsel sepetinin geleceği Muharrem ustaya emanet
Karamürsel sepetinin geleceği Muharrem ustaya emanet Dilovasın da Tarih ve Kültür Katliamı
Dilovasın da Tarih ve Kültür Katliamı Muhtar Kandaz ‘İşimi severek yapıyorum’
Muhtar Kandaz ‘İşimi severek yapıyorum’ BMGK’de Gazze’ye Ateşkes Önerisi ABD Veto’su ile Reddedildi
BMGK’de Gazze’ye Ateşkes Önerisi ABD Veto’su ile Reddedildi İsmail Kahraman Finlandiya’da Türk-İslam Kültürü, Tarım ve Tarihi Araştırdı
İsmail Kahraman Finlandiya’da Türk-İslam Kültürü, Tarım ve Tarihi Araştırdı Irak'ın bir şehrinde Türkçe resmi dil oldu!
Irak'ın bir şehrinde Türkçe resmi dil oldu! Cumhurbaşkanı Erdoğan'dan, Trump'a cevap, "Kimsenin gücü yetmez"
Cumhurbaşkanı Erdoğan'dan, Trump'a cevap, "Kimsenin gücü yetmez" Fransa’da tartışmalı Filistin bayrağı kararı!
Fransa’da tartışmalı Filistin bayrağı kararı! Samanyolu'nun 30 katı büyüklüğünde dev galaksi keşfedildi!
Samanyolu'nun 30 katı büyüklüğünde dev galaksi keşfedildi! Azerbaycan'da Yerel Seçimler Yapılıyor
Azerbaycan'da Yerel Seçimler Yapılıyor Antik su izleri bulundu: Mars'ta hayat olabilir!
Antik su izleri bulundu: Mars'ta hayat olabilir! 1960 DARBEDİNDEN 15 TEMMUZ HAİN DARBE GİRİŞİMİNE ARŞİV BELGELERİ İLE DARBELER TARİHİ KİTAP VE FOTOPRAF SERGİSİ AÇTIK
1960 DARBEDİNDEN 15 TEMMUZ HAİN DARBE GİRİŞİMİNE ARŞİV BELGELERİ İLE DARBELER TARİHİ KİTAP VE FOTOPRAF SERGİSİ AÇTIK Bahçem Çayırova’da teraryum atölyesi gerçekleştirildi
Bahçem Çayırova’da teraryum atölyesi gerçekleştirildi Başkan Çiftçi, şampiyon kadroyla bir araya geldi
Başkan Çiftçi, şampiyon kadroyla bir araya geldi Çiftçi, “Spor lisemizin inşaatı hızla devam ediyor”
Çiftçi, “Spor lisemizin inşaatı hızla devam ediyor” Çayırova’da ekipler karla mücadele çalışmalarını sürdürüyor
Çayırova’da ekipler karla mücadele çalışmalarını sürdürüyor Çiftçi, “Özel bireylerimizin azmi bizlere ilham veriyor”
Çiftçi, “Özel bireylerimizin azmi bizlere ilham veriyor” Çocuk kulüplerinde karne coşkusu
Çocuk kulüplerinde karne coşkusu Çayırovalı öğrenciler karne heyecanı yaşadı
Çayırovalı öğrenciler karne heyecanı yaşadı Başkan Ömeroğlu'ndan Miraç Kandili Mesajı
Başkan Ömeroğlu'ndan Miraç Kandili Mesajı Ankara’dan 150 Milyon TL’lik Dev Destekle Döndü
Ankara’dan 150 Milyon TL’lik Dev Destekle Döndü Bülent Ersoy, Kocaeli'de sahne aldı
Bülent Ersoy, Kocaeli'de sahne aldı Kartepe Teleferikte katlı otopark yükseliyor
Kartepe Teleferikte katlı otopark yükseliyor Bu proje Gebze'deki trafiği rahatlatacak
Bu proje Gebze'deki trafiği rahatlatacak Türkiye Yüzyılı'nın İlk Nikahlarını Kıydı
Türkiye Yüzyılı'nın İlk Nikahlarını Kıydı Başkan Bıyık’tan Zafer Bayramı mesajı
Başkan Bıyık’tan Zafer Bayramı mesajı GKM’de kahkaha tufanı
GKM’de kahkaha tufanı Güler&Şahin Ailelerinin mutlu günü
Güler&Şahin Ailelerinin mutlu günü “Engelsiz Taksi“ gelin arabası oldu
“Engelsiz Taksi“ gelin arabası oldu Milli judocu Talha Ahmet Erdem “Yılın Fotoğrafları“ oylamasına katıldı
Milli judocu Talha Ahmet Erdem “Yılın Fotoğrafları“ oylamasına katıldı